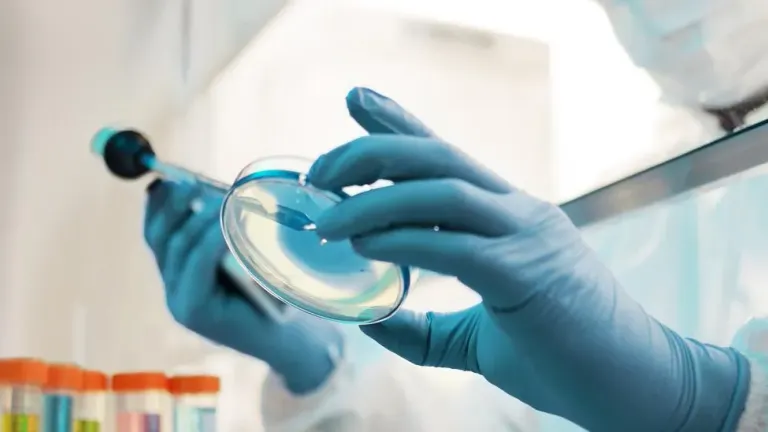
AdBlue

AdBlue® asigură un aer mai curat
AdBlue® asigură un aer mai curat
Acesta este o soluție special creată pentru motoarele Diesel ale camioanelor și autobuzelor echipate cu tehnologia SCR (Selective Catalytic Reduction – Reducere Catalitică Selectivă). Această tehnologie îi permite catalizatorului să reducă simultan toate noxele – un proces fără de care motoarele nu ar putea respecta normele Euro 6 privind emisiile de carbon. Iar Adblue® este indispensabil pentru funcționarea acestei tehnologii.
- Reduce oxidul de azot (NOx) cu 60% (Euro 5) față de nivelul de referință reprezentat de standardul Euro 3;
- Reduce particulele nocive emise cu minimum 80% (comparativ cu standardele Euro 4 şi Euro 5)
- Reduce emisiile de CO2 cu până la 7%;
- Este prietenos cu mediul;
- AdBlue® are în componență apă și uree.
Contactează-ne pentru a obține o ofertă pesonalizată
Call Center: +40 (21) 40 22250
E-mail: comercial@petrom.com